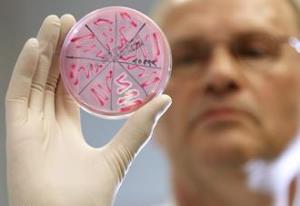

ДИЗЕНТЕРИЯ, САЛЬМОНЕЛЛЕЗ И ДРУГИЕ ОСТРЫЕ КИШЕЧНЫЕ ИНФЕКЦИИ
Расстройство стула (понос) или учащенные опорожнения кишечника с изменением характера стула (от кашицеобразного до водянистого), иногда с появлением примесей слизи, крови, является одним из характерных признаков острых кишечных инфекций (ОКИ) (дизентерии, сальмонеллезов, эшерихиозов, острых гастроэнтеритов, острых энтероколитов, пищевых токсикоинфекций, стафилококковых отравлений и других).
Причина. Дизентерию вызывают бактерии, называемые шигеллами, имеющие более 40 вариантов. В современных условиях наибольшее распространение имеют шигеллы Флекснера и Зонне. Другие ОКИ вызываются другими бактериями под названием сальмонеллы, стафилококки и т.д.
Основным источником инфекции при дизентерии и других ОКИ являются больные, а также бактерионосители (лица со стертой формой инфекции), которые выделяют возбудителя во внешнюю среду с калом.
При сальмонеллезах источниками возбудителя инфекции являются преимущественно домашние животные (рогатый скот, свиньи, домашняя птица), мясо которых заражено. Сальмонеллы часто встречаются в яйцах домашней птицы – утки (особенно), куры. Заражение происходит чаще в теплое время года при нарушении технологии обработки пищи и неправильном ее хранении. Сальмонеллы, попав в продукты питания, быстро размножаются. Количество микробов достигает такого уровня, который достаточен для заражения. При употреблении в пищу инфицированных продуктов через 6 ч – 3 сут (скрытый, инкубационный период) начинается болезнь.
Источником инфекции при стафилококковом отравлении является человек, у которого имеются гнойничковые поражения кожи: панариций, нагноившаяся рана кисти и т. п. Особенно опасно, если гнойничковые заболевания есть у кондитеров, поваров и др. Стафилококк хорошо и быстро растет на сладких продуктах (крем, кисель, компот и др.). При размножении он выделяет яд (токсин). Если человек употребляет в пищу еду, в которой имеется стафилококковый токсин, то через несколько часов начинается заболевание.
Процесс развития болезни. Непосредственной причиной заболевания являются токсины бактерий, которые попадают в желудочно-кишечный тракт с продуктами или выделяются микробами, оказавшимися в нем. Токсины действуют на различные отделы нервной системы и вызывают поступление жидкости из тканей в просвет кишки. Шигеллы, сальмонеллы и некоторые эшерихии, кроме этого, проникают в слизистую оболочку кишки, там размножаются, вызывая повреждение тканей, образование эрозий и выраженное воспаление.
В желудочно-кишечном тракте постоянно находятся микробы. Они играют защитную роль, препятствуя прикреплению и проникновению в слизистую оболочку кишечника болезнетворных микробов. При кишечных инфекциях, приеме антибиотиков и других химиопрепаратов количество и состав микробов кишечника изменяется, развивается дисбактериоз, что само по себе приводит к нарушению пищеварения и расстройству стула.
Признаки. Практически при всех ОКИ, вызываемых различными возбудителями, ведущим проявлением является расстройство стула. При этом часто наблюдается рвота. Ей предшествует тошнота. После рвоты наступает чувство облегчения. При ОКИ расстройство стула сочетается с признаками интоксикации и повышением температуры тела.
Распознавание болезни. Ведущим проявлением любой ОКИ является поражение желудка и кишечника различной степени выраженности в сочетании с интоксикацией. При значительной потере жидкости со рвотой и жидким стулом развивается обезвоживание. Информативным методом, позволяющим уточнить наличие и локализацию болезненных изменений в кишечнике, является осмотр испражнений.
Наиболее распространенной и серьезной по последствиям острой кишечной инфекцией является дизентерия. Ее следует подозревать в случае любого лихорадочного заболевания, сопровождающегося расстройством стула. Так как возбудители дизентерии поражают преимущественно толстую кишку, то признаки ее поражения: периодические схваткообразные боли в нижней части живота, чаще в левой подвздошной области, ложные позывы на дефекацию, тенезмы, ощущение неполного освобождения кишечника после дефекации, частый, скудный стул, при тяжелом течении заболевания – некаловый, состоящий из одних продуктов воспаления толстой кишки – слизи, крови, убедительно свидетельствуют об этом заболевании.
Для окончательного подтверждения диагноза или для расшифровки неясных случаев проводится посев кала для выявления возбудителя, в некоторых случаях проводится исследование крови.
Лечение. Первостепенная задача при любой ОКИ – возмещение потери жидкости и солей в соответствии со степенью обезвоживания. С этой целью рекомендуется питье, но не любой жидкости, а раствора – 1 чайная ложка поваренной соли, 4 чайные ложки сахара на 1 литр питьевой воды. Раствор принимают в слегка охлажденном виде по 100-150 мл каждые 20-30 мин общим объемом в 1,5 раза превышающем потери жидкости со рвотными массами и калом. Прием раствора продолжают до прекращения поноса. Для возмещения потери жидкости и солей более полноценны и эффективны препараты регидрон, цитраглюкосолан или гастролит, которые разводят непосредственно перед употреблением в 1 литре свежекипяченой охлажденной воды.
Для воздействия на болезнетворные микробы и снижения поступления воды и солей в кишечник из тканей эффективны бактерийные биологические препараты энтерол или биолевюр, принимаемые по 1 капсуле или пакетику (в небольшом количестве воды) 2 раза в день.
Хороший эффект наблюдается при приеме отваров кровохлебки или калгана.
Отвар кровохлебки лекарственной – 2 столовые ложки корневища и корней заливают 2 стаканом горячей воды, кипятят на слабом огне 30 мин, охлаждают 10 мин, процеживают и отжимают, принимают по 1 столовой ложке 6 раз в день после еды.
Отвар калгана дикого (лапчатки прямостоячей) – 1 столовую ложку измельченных корневищ калгана заливают 1 стаканом воды комнатной температуры, кипятят 15 мин, охлаждают, процеживают, принимают по 1 столовой ложке 3 раза в день за 1 ч до еды.
Антибиотики и другие химиотерапевтические средства при многих ОКИ не показаны и зачастую даже затягивают заболевание из-за развивающегося при этом дисбактериоза. Поэтому их назначение должно производиться только врачом, к которому следует обращаться при появлении признаков ОКИ.
Больным рекомендуется постельный режим и щадящая диета (рисовая каша на воде, сладкий чай, тертые яблоки, кисломолочные продукты) с быстрым ее расширением по мере улучшения общего состояния и нормализации стула. При этом не рекомендуются продукты, усиливающие брожение (цельное молоко, черный хлеб, бобовые, свекла, огурцы, капуста).
В квартире, особенно в санузле, должна проводиться дезинфекция хлорсодержащими препаратами.
Госпитализации подлежат больные с тяжелым течением заболевания, высокой лихорадкой, с наличием хронических заболеваний, отсутствием условий для лечения на дому.
Диспансеризация. За переболевшими ОКИ в течение 1-2 мес проводится медицинское наблюдение.
После дизентерии нередко возникает упорный запор. Во избежание этого в пищу необходимо включать продукты, оказывающие послабляющее действие, – чернослив, морковное или свекольное пюре, твердые яблоки, компот, рассыпчатую гречневую кашу. Нормализации функционального состояния кишечника способствуют некоторые настои трав:
Сбор I. Кора крушины ольховидной – 60 г, плоды солодки голой – 20 г, плоды аниса обыкновенного – 10 г, плоды фенхеля обыкновенного – 10 г. Настой употребляют утром и вечером по 0,5 стакана при задержке стула.
Сбор II. Кора крушины ольховидной – 20 г, цветки бузины черной – 20 г, плоды аниса обыкновенного – 10 г, плоды фенхеля обыкновенного – 20 г. Настой применяют по 1 стакану 2 раза в день после еды.
Сбор III. Листья мяты перечной – 20 г, цветки ромашки аптечной – 30 г, корневище аира болотного – 15 г, плоды фенхеля обыкновенного – – 15 г. Теплый настой употребляют 3 раза в день после еды при вздутии живота и спазмах кишечника.
После лечения антибактериальными препаратами при наличии признаков дисбактериоза (вздутие живота, частое отхождение газов, послабление стула), для восстановления нормальной микрофлоры кишечника рекомендуются морковь, черника, малина, смородина, шиповник, кисломолочные продукты.
Предупреждение болезни. Соблюдение правил личной гигиены, употребление доброкачественной воды и продуктов.
За лицами, соприкасавшимися с больными дизентерией, устанавливается медицинское наблюдение в течение 7 дней. Детям, посещающим дошкольные детские учреждения, проводят посев кала.

Как отличить пищевое отравление от кишечной инфекции? Разница не только в возбудителе, есть несколько ключевых признаков, которыми эти болезненные процессы отличаются.
Что такое кишечные инфекции
Кишечные инфекции — это обширная группа заболеваний, к ним относятся некоторые острые инфекционные болезни, вызываемые следующими возбудителями:
сальмонеллы — тиф, паратиф, сальмонеллёз;
- шигеллы — дизентерия;
- эшерихия коли — эшерихиоз;
- вирусы — ротавирусная инфекция.
Что такое пищевое отравление
Пищевое отравление — это острые кратковременные заболевания, в развитии которых участвуют условно-патогенные микроорганизмы или продукты их жизнедеятельности — токсины. Так, часто бывает, — после длительного нахождения готового продукта в ненадлежащих условиях (на солнце, или сутки без холодильника) некоторые микроорганизмы начинают размножаться и выделять вредные частицы — токсины. В норме небольшое количество этих бактерий или вирусов человеку вреда не причиняет. Но после гибели или в определённом критическом количестве они вызывают пищевые отравления.
Чем отличается пищевое отравление от кишечной инфекции? При пищевом отравлении сам возбудитель может отсутствовать, то есть бактерии могут погибнуть при термической обработке, но к интоксикации приводят их токсины. Нередко это готовые продукты, приобретаемые в кулинарии или кафетериях. Ещё одна категория продуктов — двух- или трёхдневные супы, блюда, оставшиеся после вечеринки. Первые блюда, несмотря на повторное кипячение, уже обсеменены микроорганизмами. Повторная термическая обработка убьёт бактерий, но после разрушения остаются продукты их жизнедеятельности, которые более устойчивы к высоким температурам и обычным способом их нельзя уничтожить.
Примером может быть:
- клостридия;
- протеус;
- стафилококк;
- клебсиелла и многие другие микроорганизмы, продуцирующие энтеротоксины.
Чем похожи пищевые отравления и кишечные инфекции
Пищевые отравления и кишечные инфекции — это одинаково неприятные заболевания, приносящие много хлопот со здоровьем. Иногда с первых симптомов без осмотра специалиста и назначения специальных исследований сложно определить чем заражён человек. Ведь пищевые отравления и кишечные инфекции очень похожи.

Поражается в первую очередь пищеварительная система. Любой из отделов может быть вовлечён в болезненный процесс: желудок, тонкий или толстый кишечник.
Все эти заболевания протекают циклически. В каждом из них можно выделить несколько основных периодов: инкубационный, разгар болезни, затихание. Общий механизм передачи — через заражённые продукты. Симптомы в большинстве случаев похожи: тошнота, многократная рвота, болезненность в области желудка и по ходу кишечника, схваткообразные боли, нарушение стула (понос). В связи с, резкой потерей жидкости из организма и вследствие влияния токсинов бактерий спустя несколько часов вовлекаются в болезненный процесс и другие системы органов. Реагирует сердечно-сосудистая и нервная система. Появляются головокружения, частый или редкий пульс, слабость, изменяется артериальное давление.
После такой характеристики каждого типа заболевания становится непонятно в чём их отличия. Что тяжелее протекает острая кишечная инфекция или пищевое отравление? Все зависит от конкретного случая. Несмотря на одинаковые проявления есть и существенные различия.
Чем отличается пищевое отравление от кишечной инфекции
Иногда даже опытному врачу сложно с первого раза определить какое заболевание у человека. Но в медицине помогают специальные методы исследования: бактериальные посевы и общие анализы. У простых людей нет возможности определить в домашних условиях какой болезни они подвержены. Поэтому нужно знать типичные отличительные признаки каждого процесса.

Все частые кишечные инфекции протекают с длительным инкубационным периодом. Это тот промежуток в течение заболевания когда человек чувствует общее недомогание, а типичных выраженных клинических проявлений ещё не наблюдается. В бактериальной или вирусной инфекции этот период длится до двух недель. Пищевое же отравление начинается спустя несколько часов после приёма некачественного продукта. Так, происходит в связи с наличием в последнем случае уже выделенных токсинов (именно они ускоряют течение болезни). При развитии же кишечной инфекции токсины выделяются спустя несколько часов после попадания в желудок микроорганизмов.
Чаще при пищевом отравлении поражаются верхние отделы пищеварительного тракта — желудок и начальные отделы тонкого кишечника. В случаях с кишечными инфекциями патологии больше подвержены тонкий и толстый кишечник. Как отличить пищевое отравление от ротавирусной инфекции? В последнем случае источником инфекции чаще бывают дети старше двух лет, в болезнь вовлекаются все отделы пищеварительной системы: появляются боли в желудке, тошнота, рвота, затем урчание и болезненность в животе, понос. 
Окончательно и полноценно диагноз можно поставить только после исследования в условиях стационара. Люди с подозрением на сильное пищевое отравление или на кишечную инфекцию должны быть госпитализированы в инфекционное отделение для полноценного лечения.
Пищевое отравление и инфекции могут имитировать друг друга, скрываться за одинаковыми симптомами. В редких случаях можно сразу самостоятельно определить их различия. Для этого понадобится время, которого у человека зачастую нет. Поэтому при первых признаках любого из этих заболеваний лучше сразу обратиться к специалисту.
Инфекционное отравление это заболевание, причиной которого являются вирусы или бактерии, например, сальмонелла, шигелла и другие. В группу кишечных инфекций входят тиф, дизентерия, сальмонелёз, эшерихиоз.
При поражении инфекцией происходит острое воспаление отдела желудочно-кишечного тракта: желудка, тонкой или толстой кишки. Все кишечные инфекции проявляются не сразу, имеют продолжительный инкубационный период. Таким периодом называют временной промежуток, во время которого человек испытывает общее недомогание, но симптомы заболевания отсутствуют. В ряде случаев этот процесс затягивается на 1,5-2 недели. Специфична динамика температуры: повышается спустя 3-4 суток, а по показателям достигает отметки 40.
Причиной инфекционных отравлений, также как и причиной обычных пищевых отравлений, является несоблюдение правил гигиены: немытые руки и посуда, нарушение сроков и температурных условий хранения продуктов.

Микроорганизмы в небольшом количестве могут содержаться в продукте и не наносить вред здоровью человека, но несоблюдение надлежащих условий, например, хранение на солнцепёке или в тёплом помещении на протяжении суток, плохая термическая обработка, приводит к росту числа бактерий и вирусов. Микроорганизмы, размножаясь, выделяют токсины, что и вызывает отравление.
Пища, употребляемая ежедневно, далеко не стерильна. Оградить себя от проникновения в органы пищеварения чужеродных микроорганизмов практически невозможно. Защитные функции организма в состоянии обезвредить некоторое количество таких бактерий, но при несоблюдении элементарных мер безопасности иммунитет не справляется, и происходят инфекционные или пищевые отравления.
Как выявить инфекционное отравление
Любое заболевание, связанное с пищеварительной системой, будь то инфекции или пищевые отравления, имеет ряд сходных симптомов. Первый и основной диарея. Остальные симптомы менее систематичны. Проявляются:
- тошнота,
- рвота,
- боли в животе разной специфики,
- повышенная температура тела.
Не исключены общая слабость и отсутствие аппетита.

Тревожными сигналами, требующими немедленной госпитализации больного, являются:
- западение глазных яблок больного,
- сухой язык,
- серый оттенок кожи,
- наличие кровяных сгустков в кале,
- продолжительность диареи более 3 дней,
- непрерывная и неконтролируемая рвота.
Серьёзную опасность составляет ситуация, когда диарея прекратилась, а рвота усилилась и температура тела резко возросла.
Виды инфекционных заболеваний
Инфекционные заболевания составляют обширную группу. Составить полный их перечень дело кропотливое, но список основных отравлений приведён в этой статье.
Сальмонеллёз инфекция, которая у всех на слуху. С бактерии рода сальмонелла связаны такие заболевания, как тиф. Вспышки интоксикаций происходят из-за употребления плохо обработанной пищи.
При интоксикации сальмонеллой возникают боль в животе, диарея, тошнота и, как следствие, рвота. Опасность заключается в том, что инкубационный период может длиться от 3 суток до 2 недель. Начинается заболевание с общих симптомов: недомогания, потери аппетита и головной боли. Могут формироваться постепенно и долго удерживаться. Течение болезни зависит от ряда факторов:
- вида сальмонеллы,
- количества съеденной пищи,
- иммунитета.
Существует риск превратиться в носителя сальмонеллы. Сальмонеллой бывают заражены молочные продукты, яйца и продукты, изготовленные с использованием таких яиц и молока. Благоприятные условия для роста бактерий этой группы создает температура +40-50 градусов. Вопреки этому они погибают при продолжительном кипячении.

Причиной возникновения дизентерии являются бактерии рода шигелл. Возбудитель действует в тканях толстой кишки, вызывая её воспаление. Развивается на продуктах при температуре 30-45 градусов. Характеризуется продолжительной жизнеспособностью. Может содержаться в молочных продуктах, фруктах, водопроводной воде. Симптомы болезни проявляются в течение 2-7 суток с момента попадания микроорганизмов в желудочно-кишечный тракт.
Бруцеллы это анаэробные бактерии, размножающиеся при температуре 35-40 градусов. Образуются в молочных продуктах, полученных от больного скота. Бактерии этого класса терпимы к холоду, погибают при высокой температуре. Являются возбудителями бруцеллёза, который характеризуется проявлением слабости, ознобом и мышечными болями.
Холерный вибрион является возбудителем острой кишечной инфекции холеры. Болезнь сопряжена с чрезмерной рвотой, приводящей к обезвоживанию, и поносом. Обезвоживание проявляется в сухости кожи, черты лица заостряются. Лечение подразумевает регидрацию организма и изоляцию заражённого, а также курс антибиотиков. Инкубационный период до 5 дней.
Холера характеризуется острым началом заболевания. Первый симптом диарея, частота позывов доходит до 10 раз в сутки. Стул постепенно становится бесцветным. Испражнения имеют зеленоватый цвет. Больной испытывает сухость во рту, его мучает жажда, впоследствии появляется головокружение, ощущение похолодания рук и ног.

Ещё одной инфекцией является ботулизм. Развивается он после попадания в организм бактерий, вырабатывающих ботулотоксин. Специфика этого возбудителя в том, что он переживает неблагоприятные условия среды в споровом состоянии. Споры могут сохраняться на протяжении долгих лет.
Бактерия гибнет при кипячении, но только при условии, что длиться оно более 30 минут. Стоит помнить о том, что возбудитель сохраняет жизнеспособность в рассолах и консервах. В связи с этим часто заражение ботулизмом происходит после употребления в пищу консервированных, в том числе и домашних, продуктов: грибов, мяса, овощей, рыбы.
Инкубационный период заболевания непродолжителен. Симптомы появляются в течение суток после заражения. Проявление болезни на начальном этапе носит неожиданный характер. Выделяют три типа начала болезни:
- гастроэнтерологический,
- глазной,
- клинический.
При первом проявляются симптомы, характерные для всех видов инфекционных отравлений. Глазной тип характеризуется нарушением зрения. Пациенты жалуются на затуманивание, потерю четкости зрения или дальнозоркость. Может проявиться дыхательная недостаточность, нарушиться сердечный ритм. Последние симптомы чрезвычайно опасны и могут привести к смертельному исходу. При клиническом типе у больного наблюдается расширение зрачков, иногда косоглазие, заражённый может жаловаться на паралич мышц и неспособность сглотнуть. Наблюдается нарушение речи, порой асимметрия лицевых мышц.

Доврачебная помощь
Первая помощь играет важную роль при любом заболевании или травме. От того, насколько быстро и правильно она оказана, зачастую зависит ход всего дальнейшего лечения. Инфекционные отравления, как уже говорилось раннее, имеют инкубационный период от 5-7 часов до 2 суток. При проявлении же первых симптомов необходимо принять меры по оказанию доврачебной помощи больному.
Доврачебная помощь заражённому инфекцией подразумевает:
- обеспечение комфортных условий пребывания в отдельной комнате в лежачем положении,
- наличие рядом с больным резервуара для рвотных масс,
- утепление организма больного покрывалом или грелкой при появлении озноба и лихорадки,
- ограждение всех членов семьи от контакта с заражённым,
- наличие тёплой кипячёной воды с растворённой в не марганцовкой или содой, которая необходима для провоцирования рвоты,
- обеспечение больного дополнительным тёплым питьём,
- принятие заражённым энтеросорбента, типа Лактофильтрум, Смекта.
При неимоверно сильных болях в желудке допустимо дать обезболивающее средство на растительной основе, но только в крайнем случае. Лучше дождаться врача. Важно помнить, что лечение больного должен заниматься квалифицированный специалист. Самолечение в подобных случаях недопустимо и может понести самые нежелательные последствия.

Диагностика заболевания
Успешное лечениеинфекционного отравления требует обнаружения его причин. При возникновении описанных выше симптомов важно обратиться к врачу, который назначит оптимальное лечение.
Первый этап лечения тщательный опрос пострадавшего. Необходимо выяснить, что употреблял в пищу больной накануне и на протяжении предыдущей недели. Уделяют внимание тем блюдам, которые не входят в привычный рацион пациента, а также купленным на рынке или употреблённым в местах общественного питания.
Собрав необходимую информацию, врач проводит осмотр, сосредотачиваясь на состоянии брюшной полости и органах пищеварения. Назначается общий анализ крови, который даст представление о тяжести инфекционного отравления. Исследованию подвергаются промывные воды желудка и фекалии. Их анализ позволяет выявить возбудителя.

Опасность самолечения
Опасность самолечения состоит в ряде факторов. Первый заключается в том, что симптомы инфекционной интоксикации схожи с симптомами обычного пищевого отравления. Последствия пищевого отравления могут пройти после 2-3 дней соблюдения диеты и употребления энтеросорбентов. Последствия инфекционного отравления намного масштабнее и при неправильном лечении приводят к летальному исходу. Кроме того, пищевые отравления не заразны, нет необходимости изолировать больного. Таким образом, правильно диагностировать заболевание может только специалист.
Средства, используемые в качестве народных рецептов, могут вызвать усиление интоксикации. Например, при отравлении ботулотоксином недопустимо употребление алкогольной продукции и спиртосодержащих веществ, поскольку воздействие отравляющих веществ возрастает в разы.
Какой врач поможет при инфекционном отравлении
Многие люди редко обращаются за помощью врача по абсурдной причине: не имеют представления, к кому и куда обратиться. Изучением бактериальных и вирусных недугов занимается инфекционист. Тем не менее, в экстренной ситуации незачем задумываться над этим вопросом. При появлении симптомов отравления достаточно позвонить в отделение скорой помощи. Бригада врачей оценит ситуацию и примет все необходимые меры.
При самостоятельной госпитализации, обращаются в дежурному терапевту поликлиники. Дальше за дело берутся специалисты. И в том, и в другом случае, первый врач, который составляет анамнез терапевт.
Видео
Как отличить пищевое отравление от инфекционного? Ответ на этот вопрос вы найдете в следующем видео.
ГАОУ ВПО «Северо-Восточный Федеральный Университет им.М. К.Аммосова».
Кафедра детских болезней и детской хирургии.
Курс инфекционных болезней детского возраста.
на тему: Дизентерия и сальмонеллез
Выполнил: студент VI курса гр.ПФ-603/1
Проверил: к.м.н., доцент кафедры
Якутск 2010 год.
Список использованной литературы
Дизентерия — инфекционное заболевание, характеризующееся поражением желудочно-кишечного тракта, преимущественно толстой кишки.
Дизентерию вызывают бактерии рода Шигелла. При разрушении микробов выделяется токсин, который играет большую роль в развитии болезни и обусловливает ее проявления.
Возбудители дизентерии отличаются высокой выживаемостью во внешней среде. В зависимости от температурно-влажностных условий они сохраняются от 3-4 суток до 1-2 месяцев, а в ряде случаев до 3-4 месяцев и даже более. При благоприятных условиях шигеллы способны к размножению в пищевых продуктах (салатах, винегретах, вареном мясе, фарше, вареной рыбе, молоке и молочных продуктах, компотах и киселях).
Дизентерия передается только от человека через загрязненные фекалиями пищу, воду, а также при контакте.
Источником возбудителя инфекции при дизентерии являются больные, а также бактерионосители, которые выделяют шигеллы во внешнюю среду с фекалиями. Больные дизентерией заразны с начала болезни. Длительность выделения возбудителя больными, как правило, не превышает недели, но может затягиваться и до 2-3 недель.
Наибольшая чувствительность к инфекции у лиц с группой крови А (II).
Ведущим фактором в развитии болезни является поступление ядов бактерий в кровь. В первую очередь поражается нервная система, а также сердечно-сосудистая система, надпочечники и органы пищеварения.
Шигеллы могут находиться в желудке от нескольких часов до нескольких суток (в редких случаях). Преодолев кислотный барьер желудка, шигеллы попадают в кишечник. В тонкой кишке они прикрепляются к клеткам кишечника и выделяют токсин, который вызывает повышенную секрецию жидкости и солей в просвет кишки. Шигеллы активно перемещаются, вызывая воспалительный процесс в тонкой кишке, который поддерживается и усугубляется действием продуцируемого шигеллами токсина. Токсин шигелл, попадает в кровь и обусловливает развитие интоксикации.
В толстую кишку шигеллы попадают несколько позже, но массивно. Это приводит к более значительному действию токсинов шигелл.
Выздоровление при дизентерии обычно сопровождается освобождением организма от возбудителя. Однако при недостаточности иммунной системы очищение организма от возбудителя затягивается до 1 месяца и более. Формируется носительство, а у части переболевших болезнь приобретает хроническое течение.
После перенесенного заболевания формируется непродолжительный иммунитет.
Инкубационный период составляет 1-7 (в среднем 2-3) дней, но может сокращаться до 2-12 часов.
Форма, вариант и тяжесть течения дизентерии зависят от путей и способов заражения, количества попавших в организм микробов, уровня иммунитета организма.
Заболевание начинается остро. В начале развивается синдром общей интоксикации, характеризующийся повышением температуры тела, ознобом, чувством жара, разбитости, снижением аппетита, головной болью, снижением артериального давления.
Поражение желудочно-кишечного тракта проявляется болями в животе, вначале тупыми, разлитыми по всему животу, имеющими постоянный характер. Затем они становятся более острыми, схваткообразными, локализуются в нижних отделах живота, чаще слева. Боли обычно усиливаются перед опорожнением кишечника.
При легком течении болезни лихорадка кратковременна, от нескольких часов до 1-2 суток, температура тела, как правило, повышается до 38°С. Больных беспокоят умеренные боли в животе, в основном перед актом опорожнения кишечника. Испражнения имеют кашицеобразную или полужидкую консистенцию, частота дефекаций до 10 раз в сутки, примесь слизи и крови не видна. Интоксикация и диарея сохраняются в течение 1-3 дней. Полное выздоровление наступает через 2-3 недели.
Среднетяжелое течение болезни — начало болезни быстрое. Температура тела с ознобами повышается до 38
39°С и держится на этом уровне от нескольких часов до 2-4 суток. Больных беспокоят общая слабость, головная боль, головокружение, отсутствие аппетита. Кишечные расстройства, как правило, присоединяются в ближайшие 2-3 часа от начала болезни. У больных появляются периодические схваткообразные боли в нижней части живота, частые ложные позывы на дефекацию, ощущение незавершенности акта дефекации. Частота стула достигает 10-20 раз в сутки. Испражнения скудные, часто состоят из одной слизи с прожилками крови. Присутствует повышенная раздражительность, бледность кожи. Язык покрыт густым белым налетом, суховатый. Интоксикация и диарея продолжаются от 2 до 4-5 дней. Полное заживление слизистой оболочки кишки и нормализация всех функций организма наступают не ранее 1-1,5 месяцев.
Тяжелое течение дизентерии характеризуется очень быстрым развитием заболевания, резко выраженной интоксикацией, глубокими нарушениями деятельности сердечно-сосудистой системы. Болезнь начинается крайне быстро. Температура тела с ознобом быстро повышается до 40°С и выше, больные жалуются на сильную головную боль, резкую общую слабость, повышенную зябкость, особенно в конечностях, головокружение при вставании с постели, полное отсутствие аппетита. Нередко появляются тошнота, рвота, икота. Больных беспокоят боли в животе, сопровождающиеся частыми позывами на дефекацию и мочеиспускание. Стул более 20 раз в сутки, нередко число дефекаций трудно сосчитать («стул без счета»). Период разгара болезни продолжается 5-10 дней. Выздоровление происходит медленно, до 3-4 недель, полная нормализация слизистой оболочки кишечника происходит через 2 месяца и более.
Диагноз хронической дизентерии устанавливается в случае, если заболевание продолжается более 3 месяцев.
Среди осложнений болезни наиболее частыми являются: инфекционно-токсический шок, инфекционно-токсическое поражение нервной системы, перитонит, пневмония.
Диагностика дизентерии
Диагностика дизентерии основывается на результатах обследования больного. Большое диагностическое значение имеет осмотр кала, при котором можно обнаружить примесь слизи с прожилками крови. Лабораторное подтверждение дизентерии проводится бактериологическим и серологическим методами. Бактериологический метод (высев шигелл из испражнений) при 3-кратном исследовании обеспечивает подтверждение диагноза у 40-60% больных. Ускоренная диагностика острых кишечных диарейных инфекций может осуществляться по обнаружению антигенов возбудителей и их токсинов в биосубстратах — слюне, моче, кале, крови. С этой целью используют иммунологические методы, обладающие высокой чувствительностью и специфичностью: иммуно-ферментный анализ (ИФА), реакция агглютинации латекса (РАЛ), реакции коагглютинации (РКА), иммунофлуоресценции (РИФ), полимеразной цепной реакции (ПЦР).
Лечение больных дизентерией должно быть комплексным и строго индивидуализированным. Постельный режим необходим, как правило, только для больных тяжелыми формами болезни. Больным со среднетяжелыми формами разрешается выходить в туалет. Больным легкими формами назначают палатный режим и лечебная физкультура.
Одним из важнейших слагаемых в комплексной терапии кишечных больных является лечебное питание. В остром периоде при значительных кишечных расстройствах назначают стол №4; с улучшением состояния, уменьшением дисфункции кишечника и появлением аппетита больных переводят на стол №2, а за 2-3 дня перед выпиской из стационара — на общий стол.
Назначать больному антибактериальный препарат необходимо с учетом сведений о «территориальном пейзаже лекарственной устойчивости», т.е. чувствительности к нему шигелл, выделяемых от больных в данной местности в последнее время. Комбинации из двух и более антибиотиков (химиопрепаратов) назначаются только в тяжелых случаях.
Продолжительность курса лечения дизентерии определяется улучшением состояния больного, нормализацией температуры тела, уменьшением кишечных расстройств. При среднетяжелой форме дизентерии курс терапии может быть ограничен 3-4 днями, при тяжелой — 4-5 днями. Сохраняющаяся в период раннего выздоровления легкая дисфункция кишечника (кашицеобразный стул до 2-3 раз в сутки, умеренные явления метеоризма) не должны служить поводом для продолжения антибактериального лечения.
Больным легком дизентерией в разгаре заболевания, протекающего с примесью слизи и крови в испражнениях, назначают один из следующих препаратов: нитрофураны (фуразолидон, фурадонин по 0,1 г 4 раза в день, эрсефурил (нифуроксазид) 0,2 г 4 раза в сутки), котримоксазол по 2 таблетки 2 раза в день, оксихинолины (нитроксолин по 0,1 г 4 раза в день, интетрикс по 1-2 таблетки 3 раза в день).
При среднетяжелом течении дизентерии назначают препараты группы фторхинолонов: офлоксацин по 0,2 г 2 раза в сутки или ципрофлоксацин по 0,25 г 2 раза в сутки; котримоксазол по 2 таблетки 2 раза в день; интетрикс по 2 таблетки 3 раза в день.
При тяжелом течении дизентерии назначают офлоксацин по 0,4 г 2 раза в сутки или ципрофлоксацин по 0,5 г 2 раза в сутки; фторхинолоны в комбинации с аминогликозидами; аминогликозиды в комбинации с цефалоспоринами.
При дизентерии Флекснера и Зонне назначают поливалентный дизентерийный бактериофаг. Препарат выпускается в жидком виде и в таблетках с кислотоустойчивым покрытием. Принимают за 1 час до еды внутрь по 30-40 мл 3 раза в день или по 2-3 таблетки 3 раза в день.
Читайте также:

сальмонеллы — тиф, паратиф, сальмонеллёз;
сальмонеллы — тиф, паратиф, сальмонеллёз;




